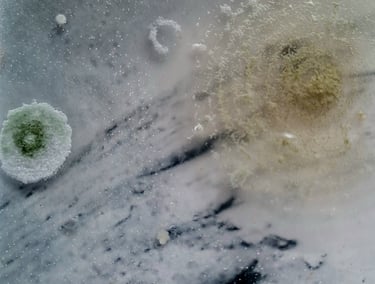
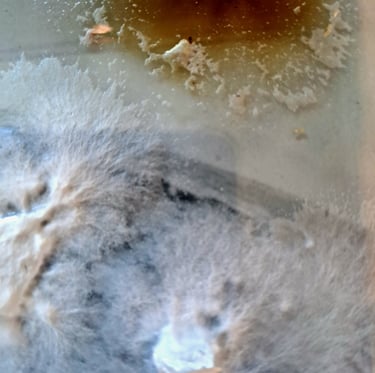

Part of an ongoing collaboration with Sahjan Kooner. Fungi coaxed to grow over a range of archival images, sealed in resin and yet still showing evidence they're metabolising, breathing... just slowed down... in stasis.
dankEconogy1_ALIENVillage - Sahjan Kooner
Eastside Projects, 86 Heath Mill Lane, Birmingham B9 4AR (7 October - 16 December 2023)
Photos: Stuart Whipps

CRYOphage
Get in touch for collaborations and inquiries
© 2025. All rights reserved.